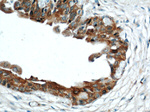
C9orf78 Antibody in Immunohistochemistry (Paraffin) (IHC (P))
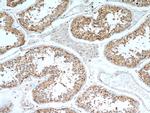
C9orf78 Antibody in Immunohistochemistry (Paraffin) (IHC (P))

Search
Proteintech
C9orf78 Polyclonal Antibody
{{$productOrderCtrl.translations['antibody.pdp.commerceCard.promotion.promotions']}}
{{$productOrderCtrl.translations['antibody.pdp.commerceCard.promotion.viewpromo']}}
{{$productOrderCtrl.translations['antibody.pdp.commerceCard.promotion.promocode']}}: {{promo.promoCode}} {{promo.promoTitle}} {{promo.promoDescription}}. {{$productOrderCtrl.translations['antibody.pdp.commerceCard.promotion.learnmore']}}
产品信息
14496-1-AP
种属反应
宿主/亚型
分类
类型
抗原
偶联物
形式
浓度
纯化类型
保存液
内含物
保存条件
运输条件
产品详细信息
The MW of this protein is 34 kDa, and this antibody specifically recognizes the 34 kDa protein. This antibody works well in WB, IHC and IF applications.
Immunogen sequence: MPVVRKIFR RRRGDSESEE DEQDSEEVRL KLEETREVQN LRKRPNGVSA VALLVGEKVQ EETTLVDDPF QMKTGGMVDM KKLKERGKDK ISEEEDLHLG TSFSAETNRR DEDADMMKYI ETELKKRKGI VEHEEQKVKP KNAEDCLYEL PENIRVSSAK KTEEMLSNQM LSGIPEVDLG IDAKIKNIIS TEDAKARLLA EQQNKKKDSE TSFVPTNMAV NYVQHNRFYH EELNAPIRRN KEEPKARPLR VGDTEKPEPE RSPPNRKRPA NEKATDDYHY EKFKKMNRRY (1-289 aa encoded by BC007664)
靶标信息
Involved in the regulation of telomeric heterochromatin assembly and control of telomere length. [UniProt]
仅用于科研。不用于诊断过程。未经明确授权不得转售。
篇参考文献 (0)
生物信息学
蛋白别名: Hepatocellular carcinoma-associated antigen 59; Splicing factor C9orf78; uncharacterized protein C9orf78 homolog
基因别名: bA409K20.3; C9orf78; HCA59; HSPC220
UniProt ID: (Human) Q9NZ63
Entrez Gene ID: (Human) 51759, (Rat) 311855